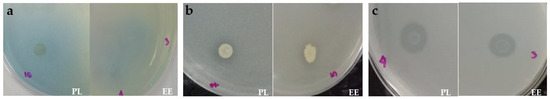

Abstract
In the Philippines, the use of non-native earthworm species in vermicomposting is popular. Given that the country is a vital geographical resource for earthworm diversity, the study of earthworm species to establish the potential of their vermicasts in agricultural applications is essential. In this study, the bacteria associated with the vermicasts of the recently described indigenous species, Pheretima losbanosensis, were investigated using next-generation sequencing, community-level physiological profiling, and NPK activity screening. The results showed diverse bacterial species belonging to the phyla Proteobacteria, Bacteroidetes, Acidobacteria, Actinobacteria, Chloroflexi, Firmicutes, Gemmatimonadetes, Nitrospirae, Planctomycetes, Spirochaetes, Thermodesulfobacteria, and Verrucomicrobia. Higher diversity and carbon substrate utilization (p < 0.05) of amines and amides, phenolic compounds, polymers, and carboxylic and acetic acids were exhibited by the bacterial communities of P. losbanosensis compared to those of Eudrilus eugeniae. Likewise, bacteria (n = 25) isolated from P. losbanosensis vermicasts had higher nitrogen fixation and phosphate and potassium solubilization activities (p < 0.05) than the bacteria (n = 20) isolated from E. eugeniae vermicasts. Overall, our results indicate that the diverse bacterial communities inhabiting the vermicasts of P. losbanosensis have nutrient mineralization and carbon substrate utilization activities that may have applications in sustainable agriculture as a potential organic input to promote plant growth and improve soil substrate.
1. Introduction
Vermicomposting is the process of using earthworms for the degradation of materials, producing vermicasts with beneficial applications primarily in agriculture. Vermicasts excreted by earthworms were reported to be inhabited by diverse species of bacteria such as those obtained from Aporrectodea caliginosa Savigny, 1826 [1,2,3]; Aporrectodea trapezoides Dugés, 1828 [4]; Eisenia andrei Bouché, 1972 [5,6,7,8]; Eisenia fetida Savigny, 1826 [1,9,10]; Eudrilus eugeniae Kinberg, 1867 [9]; Libyodrilus violaceus Beddard, 1891 [11]; Lumbricus rubellus Hoffmeister, 1843 [12]; Lumbricus terrestris Linnaeus, 1758 [1,2]; Perionyx excavatus Perrier, 1872 [13]; and Pontoscolex corethrurus Müller, 1857 [14].
In general, vermicasts are characterized as having higher pH and moisture content than soil, along with greater enrichment by carbon, nitrogen, phosphorus, ammonium, polysaccharides, exchangeable cations (Ca2+, Mg2+, and K+), and humus [15,16,17,18]. The presence of higher nutrient content in vermicasts is associated with partial organic matter decomposition during gut passage, resulting in the conversion of these nutrients into available forms [19]. Water absorption, water holding capacity, enzymatic activities, microbial biomass (Cmic), metabolic quotient, cation exchange capacity, heavy fraction polysaccharide, soil organic matter, basal soil respiration, and base saturation were also higher in vermicasts [15,16,17,18,19,20]. Organic matter mineralization indicated by the Cmic/Corg ratio, wherein a higher ratio signifies higher activity, explains the involvement of vermicasts in nutrient mineralization resulting in the availability of more nutrients [19]. Earthworm vermicasts therefore offer favorable effects for improving soil properties and fertility, which in turn contribute to better plant growth and yield [18].
The application of vermicasts produced through vermicomposting provides numerous benefits to soil and plants [15,21], as shown by studies on cucumber, pepper, tomato, strawberry, marigold, and ornamental plants [22,23,24,25,26,27,28], to name a few. The yield and quality of cucumber or Cucumis sativus were improved upon the application of E. fetida vermicasts compared to fertilizers (organic and inorganic) [28]. Vermicasts produced by E. fetida, E. eugeniae, and Pe. excavatus were found to significantly increase the length of shoot and internode as well as the number of branches and leaves of Capsicum annuum when compared to plants treated with synthetic plant growth regulators [27]. Leaf areas, plant shoot biomass, and marketable weight of pepper and strawberries were increased when treated with vermicomposts [22,23]. An increase in the number of flowers and plant runners of strawberries was also evident. Shoot dry weights of tomato and marigold grown in vermicomposts of Eisenia spp. were comparable to those in a commercial horticultural medium (Metro-Mix 360) [24]. Improved length, initiation, number, and weight of the roots of an ornamental plant, Codiaeum variegatum, were observed when grown with vermicasts of Lampito mauritii Kinberg, 1867 and Perionyx ceylanensis Michaelsen, 1904 than the control peat moss [26]. These effects were associated with the high NPK content of earthworms’ vermicasts.
In spite of the known benefits of vermicasts, information on the physiological profiles and nutrient mineralization activities of their associated bacterial communities is lacking. In the Philippines, indigenous earthworm species are often neglected because vermicomposting usually involves the use of the non-native E. eugeniae since its introduction from Africa in the 1980s [29,30]. This epigeic species feeds on organic matter and occupies the surface litter, and is popular for its rapid growth, voracious feeding, and high tolerance to unfavorable conditions [7]. Currently, it is being promoted by the Philippines’ Department of Agriculture for its temperature preference of 25–30 °C, which is common in tropical countries [7,29]. Studies have proven the significant impact of E. eugeniae vermicasts as feed for Nile tilapia (Oreochromis niloticus) [31] and as fertilizer for lowland and upland rice [29,30,31]. However, E. eugeniae may pose a threat to native species being displaced. In this work, the diversity, physiological profiles, and nutrient mineralization activities of the bacteria associated with the vermicasts of P. losbanosensis Aspe and Obusan, 2023, a Philippine indigenous species, were assessed. Investigating the microbial activities in their vermicasts is important to establish their potential for sustainable agriculture. The Philippine archipelago is a vital geographical resource for indigenous earthworm diversity; however, there are no published studies and baseline data yet on their vermicasts and their associated bacteria as of the time of writing. To the best of our knowledge, this is the first report on the bacterial communities present in the vermicasts of an indigenous earthworm in the country, supporting the benefits of their utilization and potential application of their vermicasts as organic input in agriculture. Figure 1 illustrates the schematic diagram of this study.

Figure 1.
Schematic diagram of the study.
2. Materials and Methods
2.1. Collection of Earthworm Samples
Adult P. losbanosensis earthworms were collected from Folia Tropica, a vermicompost facility in Los Baños, Laguna, Philippines (14.158882° N, 121.255919° E), that mass produces vermicasts for commercial purposes. Twenty adult earthworms were individually handpicked and placed in a polypropylene container [32]. Samples were immediately transported to the laboratory for processing. For vermicast collection, earthworms were kept in a container provided with aeration and moist sterile filter paper. After 12–15 h, fresh vermicasts were collected from the containers [33]. Adult E. eugeniae earthworms served as a control, collected from the vermicompost facility of the Diliman Environmental Management Office (DEMO), formerly known as the Task Force Solid Waste Management (TFSWM), University of the Philippines Diliman (UPD), Quezon City, Philippines (14°39′32.9″ N 121°04′02.1″ E).
2.2. Earthworm Species Morphological Diagnosis
2.2.1. Eudrilus Eugeniae
Body length 90–185 mm, tapering posteriorly, becoming thinly flattened at terminal end (Figure 2). Width 4–8 mm. Segments 161–211. Red-brown dorsum fading posteriorly; anterior with bright blue/green iridescent sheen from cuticle diffraction, ventrum beige, clitellum darker (sometimes lighter) than surroundings. Prostomium small, open epilobous. Dorsal pores, absent. Eight setae per segment from segment 2, closely paired. Clitellum covers segments 13, 14, 15–18, usually 13, 14–18, and interrupted ventrally. Male pores in 17 on tips of longitudinally grooved, tapering, eversible penis in large ventral chambers. Female pores combined with modified ‘spermathecal pores’, lateral, presetal in 14 as raised intrasegmental openings. Genital markings on 17 between male pores, faintly repeated in 18. Weakly muscular gizzard in v. Calciferous glands in x and xi. Intestine originates in or around xiv. Caeca absent. Male organs holandric with two large, unpaired sacs seen ventrally in x and xi, each containing a testis anteriorly and funnels posteriorly [34].

Figure 2.
Adult E. eugeniae earthworms collected from the vermicompost facility of the University of the Philippines Diliman, Quezon City, Philippines.
2.2.2. Pheretima losbanosensis
Large brown worms with adult size of 220–228 mm × 8–9 mm (Figure 3); equators pigmented; three pairs of spermathecal pores at 6/7–8/9; distance between spermathecal pores and between male pores 0.18 and 0.15 circumference apart ventrally, respectively; setae on vii and xx 26–36 and 56–66, respectively. Spermathecae paired in vii, viii, and ix, with nephridia on ducts; each spermatheca small with ovate ampulla, stout muscular duct, stalked diverticulum attached to duct near ampulla, terminating in ovate receptacles, stalks long and thin, some with convolutions; prostates small in xvii to xix; penis present [35].

Figure 3.
Adult P. losbanosensis earthworms collected from the vermicompost facility of Folia Tropica, Los Baños, Laguna, Philippines.
2.3. DNA Extraction and Next-Generation Sequencing
Total DNA was extracted from 0.25 g of vermicasts using the NucleoSpin® Soil kit (Toronto, ON, Canada) following the manufacturer’s instructions. The concentration of extracted DNA was measured using a NanoDrop spectrophotometer and submitted to Macrogen for next-generation sequencing (NGS). The V3-V4 hypervariable region of the 16S rRNA gene was sequenced using the Illumina MiSeq platform [4,36,37].
Raw DNA reads generated through NGS were analyzed. For assembly, paired-end reads were merged using FLASH (1.2.11) or Fast Length Adjustment of Short Reads. For pre-processing and clustering, CD-HIT-OTU was used for three-step clustering. Short reads were filtered out and extra-long tails were trimmed. Filtered reads were clustered at 100% identity. Chimeric reads were screened. The remaining representative reads from non-chimeric clusters were clustered into OTUs at 97% similarity at the species level [4,36,37]. Taxonomy assignment and diversity analysis were carried out using QIIME (Quantitative Insights into Microbial Ecology). Taxonomy assignment for the clustered OTUs was performed using QIIME-UCLUST to identify the taxonomic composition for each sample from phylum to species levels. Diversity analysis was carried out to determine the alpha diversity metrics including Chao1, Shannon, Simpson, and Good’s coverage.
2.4. Community-Level Physiological Profiling (CLPP) of Bacteria in Vermicasts
The physiological profiles of bacteria present in vermicasts of P. losbanosensis were determined [38]. Briefly, 1 g portions of vermicasts were suspended in 99 mL sterile distilled water for 20 min at 20 °C. After incubation for 30 min at 4 °C, 150 µL was inoculated into each well of Biolog EcoPlate with 31 carbon sources (β-methyl-D-glucoside, D-galactonic acid γ-lactone, L-arginine, pyruvic acid methyl ester, D-xylose, D-galacturonic acid, L-asparagine, Tween 40, i-erythritol, 2-hydroxy benzoic acid, L-phenylalanine, Tween 80, D-mannitol, 4-hydroxy benzoic acid, L-serine, α-cyclodextrin, N-acetyl-D-glucosamine, γ-amino butyric acid, L-threonine, glycogen, D-glucosaminic acid, itaconic acid, glycyl-L-glutamic acid, D-cellobiose, glucose-1-phosphate, α-keto butyric acid, phenylethylamine, α-D-lactose, D,L-α-glycerol phosphate, D-malic acid, putrescine) in three replications and incubated at 25 °C. Substrate utilization was indicated by the formation of a purple color upon the reduction of tetrazolium violet redox dye. Absorbance (OD) was measured at 590 nm every 24 h for 5 d. Average well-color development (AWCD), richness (R), and Shannon–Weaver index (H) were calculated using the absorbance data measured after 48 h, essential for microbial growth and color development. R was determined as the total number of oxidized carbon substrates with OD values ≥ 0.2. AWCD and H were calculated as follows, where ODi denotes optical density from each well and pi denotes the ratio of ODi to ∑ODi:
AWCD = ∑ ODi/31 H = −∑pi(lnpi)
All data analyses were performed using the statistical software R (version 4.3.0), specifically RStudio 5695.3.1.0 [39,40,41]. Analysis of variance (ANOVA) and post hoc Tukey’s HSD (honest significant difference) test at p ≤ 0.05 were performed to compare the AWCD, R, and H of the two earthworm species. Carbon substrate utilization patterns (CSUPs) were visualized using a heatmap generated by the gplots package.
2.5. Bacterial Isolation from Vermicasts
Bacteria were isolated from the vermicasts of P. losbanosensis through the pour plate method [1,42]. Briefly, 0.5 g portions of vermicasts were suspended in 2.5 mL sterile distilled water (1:5 ratio) and vortexed for a few minutes or until homogenized. Then, 1 mL of the homogenized sample was added to 9 mL of sterile distilled water to perform serial dilutions up to 10−3. From the last dilution, a 0.1 mL aliquot was inoculated onto nutrient agar (NA) with nystatin and incubated for 18–72 h at 37 °C and for 7 d in anaerobic conditions at room temperature. Colonies with distinct morphologies were selected and repeatedly sub-cultured for purification [1,11,32,42,43].
2.6. Bacterial Nutrient Mineralization Screening
Pure isolates were screened for nutrient mineralization, including nitrogen (N) fixation and phosphate (P) and potassium (K) solubilization, using nitrogen-free malate media supplemented with bromothymol blue (BTB), Pikovskaya’s agar (HiMedia M520), and Aleksandrow agar (HiMedia M1996), respectively. In each medium, 10 μL of fresh culture of bacteria from nutrient broth (NB) was spot-inoculated and incubated for 5 d at 37 °C. Daily observation was performed to check for a blue coloration zone indicating N fixation [44] and a clearing zone for P and K solubilization. The solubilization index (SI) was calculated based on the diameters of the colony and clearing zones [45,46,47]. ANOVA and post hoc Tukey’s HSD test at p ≤ 0.05 were performed to compare the coloration zone (N) and SI (P and K) values obtained using the statistical software R (version 4.3.0) through RStudio 5695.3.1.0.
3. Results and Discussion
3.1. Bacterial Community Profile of Vermicasts
The bacterial community targeted by the 16S V3-V4 region of the ribosomal DNA gene yielded 327,040 sequences from P. losbanosensis vermicasts (PL) and 200,984 sequences from E. eugeniae vermicasts (EE) (Table 1). After assembly, preprocessing, and clustering, 4734 and 6111 sequences were obtained and clustered into 280 and 133 OTUs from PL and EE, respectively (Table 2). The Good’s coverage of the samples was found to be 1.0 (PL) and 0.9997 (EE) (mean ± SD), which implies that most of the diversity was captured. The non-parametric Shannon index showed that more diverse species of bacteria were found in PL (6.6834) than in EE (4.2816).

Table 1.
The total number of bases, reads, GC (%), AT (%), Q20 (%), and Q30 (%) of P. losbanosensis (PL) and E. eugeniae (EE) vermicasts generated by next-generation sequencing using Illumina MiSeq.

Table 2.
Alpha diversity indices for bacterial communities in the P. losbanosensis (PL) and E. eugeniae (EE) vermicasts generated by QIIME.
Taxonomic assignment using QIIME-UCLUST resulted in a total of 12 bacterial phyla in the complete dataset, with 11 phyla in PL and 7 phyla in EE vermicasts (Figure 4). Major bacterial phyla identified were Bacteroidetes (41.6%) and Proteobacteria (35.3%). Proteobacteria is dominant in PL but Bacteroidetes dominate in EE. The other phyla include Acidobacteria, Actinobacteria, Chloroflexi, Firmicutes, Gemmatimonadetes, Nitrospirae, Planctomycetes, Spirochaetes, Thermodesulfobacteria, and Verrucomicrobia. Spirochaetes were not found in PL, while EE vermicasts were not inhabited by five phyla: Acidobacteria, Actinobacteria, Gemmatimonadetes, Nitrospirae, and Thermodesulfobacteria.

Figure 4.
Bacterial phyla (a) and dominant families (b) in P. losbanosensis (PL) and E. eugeniae (EE) vermicasts generated by QIIME-UCLUST.
A total of 83 bacterial families were present in PL dominated by Vicinamibacteriaceae (12.0%), Cytophagales (8.72%), Thioprofundaceae (5.39%), Gammaproteobacteria (4.88%), Geodermatophilaceae (4.63%), Zoogloeaceae (4.14%), and Cytophagaceae (3.91%) (Figure 4). On the other hand, EE was inhabited by 37 families dominated by Flavobacteriaceae (53.56%), Cellvibrionaceae (9.11%), Moraxellaceae (6.50%), Caulobacteraceae (4.40%), and Pseudomonadaceae (3.80%). Genera Vicinamibacter (9.63%), Chryseolinea (8.72%), Thioprofundum (5.39%), Acidibacter (4.88%), Blastococcus (4.56%), and Azoarcus (4.14%) cover large parts of the 128 bacterial genera in PL, while Myroides (34.32%), Confluentibacter (11.34%), Cellvibrio (9.11%), Acinetobacter (6.35%), and Flavobacterium (4.17%) were relatively more abundant among the 50 genera in EE (Figure 5). In total, 153 and 68 species were present in PL and EE, respectively. Major bacterial species identified in PL were Vicinamibacter silvestris (9.63%), Chryseolinea serpens (8.72%), Thioprofundum lithotrophicum (5.32%), Acidibacter ferrireducens (4.88%), Blastococcus saxobsidens (4.56%), and Azoarcus olearius (4.06%). EE vermicasts were dominated by Myroides marinus (33.87%), Confluentibacter lentus (11.34%), Cellvibrio japonicus (7.15%), and Acinetobacter rudis (6.35%).

Figure 5.
Dominant bacterial genera (a) and species (b) in P. losbanosensis (PL) and E. eugeniae (EE) vermicasts generated by QIIME-UCLUST.
3.2. Physiological Profiles of Bacteria in Vermicasts
The AWCD and H indices of bacterial communities of PL (1.996 A590nm; 3.328 A590nm) were significantly higher (p < 0.05) than those of EE (1.042 A590nm; 3.216 A590nm) (Figure 6). The richness index showed that the bacterial communities in both vermicasts utilized all 31 carbon substrates. CSUPs (Figure 7 and Figure 8) of the two earthworm species showed that the bacterial communities in PL have significantly higher (p < 0.05) utilization of amines and amides (1.172 A590nm; phenylethylamine), phenolic compounds (1.088 A590nm; 2-hydroxy benzoic acid,) polymers (1.067 A590nm; tween 80 and alpha-cyclodextrin), and carboxylic and acetic acids (1.047 A590nm; D-galacturonic acid). On the other hand, significantly higher (p < 0.05) utilization of carbohydrates (1.160 A590nm; N-acetyl-D-glucosamine, D-mannitol, Beta-methyl-D-glucoside, and D-cellobiose) and amino acids (1.100 A590nm; L-asparagine and L-serine) were shown by the bacterial communities in EE.

Figure 6.
Average well-color development (AWCD), richness (R), and Shannon–Weaver index (H) of carbon substrate utilization by P. losbanosensis (PL) and E. eugeniae (EE) vermicasts’ bacterial communities after 48 h of incubation (n = 3). Vertical bars represent the standard error of the mean. Means separated by different letters are significantly different (Tukey’s mean separation test, p < 0.05).

Figure 7.
Carbon substrate utilization patterns (CSUPs) of P. losbanosensis (PL) and E. eugeniae (EE) vermicasts’ bacterial communities after 48 h of incubation (n = 3). Vertical bars represent the standard error of the mean. Means separated by different letters are significantly different (Tukey’s mean separation test, p < 0.05).

Figure 8.
Carbon substrate utilization patterns (CSUPs) of P. losbanosensis (PL) and E. eugeniae (EE) vermicasts’ bacterial communities after 48 h of incubation (n = 3).
Community-level physiological profiling allows the assessment of the functional diversity or metabolic potential of a microbial community as represented by carbon substrate utilization. The oxidative ability of a microbial community is indicated by the AWCD values in relation to the R index, signifying the number of oxidized substrates [48]. PL bacterial communities (1.996 A590nm) showed higher AWCD values denoting their oxidative ability compared to EE (1.796 A590nm), but both were able to oxidize all carbon substrates with an R value of 31. On the other hand, the H index measures the diversity of substrate utilization (DSU) in relation to the efficiency of microorganisms in substrate degradation [49]. Thus, a higher H value (3.356 A590nm) confirmed that bacterial communities present in PL were more efficient in the degradation of carbon substrates. These results show that bacterial communities associated with the vermicasts of P. losbanosensis with higher AWCD, R, and H indices possess higher functional diversity or metabolic potential [38].
To date, little is known about the physiological profiles of bacteria in earthworm vermicasts, except in the case of Lumbricidae earthworms such as Allolobophora chlorotica Savigny, 1826, A. caliginosa, and L. terrestris, which were reported to accelerate functional diversity in their vermicasts [50]. Their vermicasts had an AWCD value of 0.94 A590nm, which was significantly higher than the bulk soil and transitional zone (0.11–0.12 A590nm) of their burrow system. Moreover, groups of carbon substrates such as amino acids, carboxylic acids, carbohydrates, polymers, and miscellaneous compounds were favored in vermicasts and burrow systems as compared to bulk soil.
3.3. Nutrient Mineralization Activities of Bacteria in Vermicasts
A total of 25 bacterial isolates obtained from the vermicasts of P. losbanosensis and 20 isolates from E. eugeniae were subjected to plate-based screening assay of nutrient mineralization. Results showed 14 bacteria (PL: 8; EE: 6) capable of fixing N on nitrogen-free malate media, as indicated by blue-colored zones with maximum activity (p < 0.05) of 29 mm produced by isolate PL16 than the 9 mm produced by EE3 and EE4 (Figure 9 and Figure 10). Clearing zones produced by 18 isolates (PL: 10; EE: 8) confirmed P solubilization on Pikovskaya’s agar with isolate PL20 having a significantly higher (p < 0.05) SI value of 2.57 than EE5 (2.27) (Figure 9 and Figure 11). Clearing zones were also observed on Aleksandrow agar, showing the ability of seven isolates (PL: 3; EE: 4) to solubilize K with a significantly higher (p < 0.05) SI value of 3.3 produced by isolate PL4 than EE3 (2.67) (Figure 9 and Figure 12). Based on these data, bacteria isolated from the vermicasts produced by the indigenous earthworms showed higher plate-based NPK mineralization activities.
Figure 9.
Blue coloration and clearing zones produced by representative bacterial isolates from P. losbanosensis (PL) and E. eugeniae (EE) vermicasts capable of N fixation on nitrogen-free malate media (a), P solubilization on Pikovskaya’s agar (b), and K solubilization on Aleksandrow agar (c) after 5 d of incubation (n = 2). Zones were first observed after 24 h of incubation, with increasing diameters as time progressed.

Figure 10.
Zone of blue coloration produced by bacteria isolated from P. losbanosensis (PL) and E. eugeniae (EE) vermicasts capable of N fixation on nitrogen-free malate media after 5 d of incubation (n = 2). Vertical bars represent the standard error of the mean. Means separated by different letters are significantly different (Tukey’s mean separation test, p < 0.05).

Figure 11.
P solubilization index (SI) of bacteria isolated from P. losbanosensis (PL) and E. eugeniae (EE) capable of P solubilization on Pikovskaya’s agar after 5 d of incubation (n = 2). Vertical bars represent the standard error of the mean. Means separated by different letters are significantly different (Tukey’s mean separation test, p < 0.05).

Figure 12.
K solubilization index (SI) of bacteria isolated from P. losbanosensis (PL) and E. eugeniae (EE) capable of K solubilization on Aleksandrow agar after 5 d of incubation (n = 2). Vertical bars represent the standard error of the mean. Means separated by different letters are significantly different (Tukey’s mean separation test, p < 0.05).
The presence of N-fixing bacteria (NFB) in earthworms’ vermicasts was previously reported in E. fetida, namely Azotobacter, Beijerinckia, and Derxia [10], and in E. eugeniae, including Aeromonas caviae and Bacillus xiamenensis [51]. The presence and activity of NFB in vermicasts have been confirmed to increase N mineralization in relation to the continuous casting activity of earthworms [52] as well as higher levels of microbial respiration, population, and enzyme activity [9]. Also, N mineralization involving NH4+ production is directly proportional to the size of vermicasts [53]. This was the case in Amynthas khami Thai, 1984, wherein an increase in NH4+ was observed from vermicasts with increasing size brought by fixation, denitrification, and remobilization in the microbial biomass. In contrast, the stabilization of vermicasts linked with a high rate of nitrification resulted in the decline in NH4+ content obtained from L. rubellus vermicasts [21]. Reduced ammonia content and a higher level of nitrate were also observed, wherein 96% of mineral N in fresh vermicasts is composed of ammonia converted to nitrate via nitrification [54].
Consistent with the results of the present study, vermicasts of E. eugeniae were reported to have P-solubilizing microbes such as Streptosporangium species [55] and A. caviae and B. xiamenensis [51]. Microbes capable of P solubilization were also isolated from other earthworm species such as Po. corethrurus vermicasts with acid phosphatase enzymes and rock phosphate-solubilizing microbes [14]. High phosphatase activity was also evident among L. mauritii, Pe. excavatus, Po. corethrurus, and Pheretima elongata Perrier, 1872, causing the release of more inorganic P through mineralization [56]. Among these, vermicasts of Pe. excavatus showed the highest phosphatase activity, indicative of its potential in organic matter mineralization. The passage of organic matter in the gut converts some P into a more available form, which is continued in vermicasts by P-solubilizing microbes [57].
Vermicomposting offers beneficial applications in agriculture, primarily in enhancing plant growth and soil substrate [15,16,17,18,19,20,21,22,23,24,25,26,27,28] owing to the diverse species of bacteria [1,2,3,4,5,6,7,8,9,10,11,12,13,14] and high nutrient content [15,16,17,18,19] present in vermicasts. Bacteria capable of nitrogen fixation and phosphate and potassium solubilization make the essential macronutrients readily available for plant uptake, resulting in improved quantity and quality of growth [15,16,17,18,19,20,21,22,23,24,25,26,27,28,58,59]. Microbial activities also influence soil restoration and augment soil structure, including increased porosity, water-holding capacity, and aggregate stability [60,61,62]. More than 170 vermicomposting systems were established in Cuba by 1994 replacing the need for 40 tons/hectare of livestock manure with 4 tons/hectare of vermicomposts. In Havana, Vivero Alamar Organoponico produces 300 tons of vermicasts per year. Production of a ton of organic fertilizer costs around USD 0.55, considerably cheaper than purchasing chemical fertilizer (40 USD/ton). In Sancti Spiritus, Finca de Casimiro established in 1993 also employed earthworms in the successful remediation of severely contaminated land used to be planted with tobacco [63]. This highlights the potential of vermicomposting as a promising alternative to chemical and synthetic inputs for sustainable agriculture. In the Philippines, the Los Baños Folia Tropica vermifacility in Laguna Province has been successfully culturing P. losbanosensis and mass-producing vermicasts for commercial purposes for more than a decade already. Based on the observations of Dr. Raymundo Lucero, who is managing the facility, indigenous earthworms in his facility have better cast yields and improved plant growth in comparison with E. eugeniae.
Interestingly, our results uncover the presence of diverse bacterial communities inhabiting the vermicasts of P. losbanosensis possessing nutrient mineralization and carbon substrate utilization activities, which are significantly higher than those of E. eugeniae. Bacterial species identified herein, including A. ferrireducens [64], Arboricoccus pini [65], A. olearius [66,67,68], Bradyrhizobium namibiense [69], Chitinophaga ginsengisegetis [70], Chitinophaga polysaccharea [71], Flavobacterium enshiense [72], Frankia discariae [73], Geobacter luticola [74], Herbaspirillum robiniae [75,76,77], Luteitalea pratensis [78], Methylosinus trichosporium [79], Nitrospira moscoviensis [80], Paludibaculum fermentans [78], Pelobacter propionicus [81], Pseudomonas oryzae [82], Roseiarcus fermentans [83], and Solirubrobacter ginsenosidimutans [84], were reported to be beneficial in the growth of plants like rice, grape, peanut, pine, blueberry, duckweed, legumes, beans, grass, and ornamental plants. Moreover, species of bacteria identified from the vermicasts of P. losbanosensis were also reported to be involved in soil bioremediation and the improvement of soil substrate such as Azoarcus tolulyticus [85,86,87], Caldimonas manganoxidans [88], Chitinophaga jiangningensis [89,90], Dehalogenimonas lykanthroporepellens [91], Desulfuromonas palmitatis [92,93], Ferruginibacter alkalilentus [94], Geobacter metallireducens [95], Geobacter sulfurreducens [96], Hyphomicrobium aestuarii [97], Immundisolibacter cernigliae [98], Methylibium petroleiphilum [99,100,101,102], Methylosinus trichosporium [103], Nocardioides islandensis [104], Phenylobacterium panacis [105], Povalibacter uvarum [106], Propionivibrio limicola [107], Pseudaminobacter manganicus [108], Steroidobacter denitrificans [109,110], Thermostilla marina [111], and Thiohalobacter thiocyanaticus [112]. These highlight the presence of beneficial bacteria in the vermicasts of P. losbanosensis that are involved in plant growth promotion, soil bioremediation, and soil substrate improvement, which are vital in sustainable agriculture practices.
4. Conclusions
Vermicasts of the recently described indigenous earthworm species, P. losbanosensis, were investigated and compared with E. eugeniae vermicasts. P. losbanosensis vermicasts harbor diverse bacterial communities comprising 153 different species belonging to the phyla Proteobacteria, Bacteroidetes, Acidobacteria, Actinobacteria, Chloroflexi, Firmicutes, Gemmatimonadetes, Nitrospirae, Planctomycetes, Spirochaetes, Thermodesulfobacteria, and Verrucomicrobia. The Shannon index confirmed that more diverse species of bacteria were found in P. losbanosensis. Physiological profiles of the bacterial communities in the vermicasts of P. losbanosensis were shown through the utilization of all 31 carbon substrates, primarily the amines and amides, phenolic compounds, polymers, and carboxylic and acetic acids, with higher AWCD and H index indicating higher functional diversity or metabolic potential. Among the 45 isolates, bacteria from the vermicasts of P. losbanosensis were found to be more efficient in plate-based NPK mineralization, showing the largest blue coloration zone, thus confirming nitrogen fixation and the highest phosphate and potassium solubilization index. Overall, this study unveiled that vermicasts produced by indigenous earthworms are better than those of non-native species in terms of having (1) more diverse bacterial communities, (2) higher functional diversity or metabolic potential, and (3) higher NPK mineralization activities. These results highlight the potential of P. losbanosensis vermicasts as an organic input to promote plant growth and improve soil substrate. Hence, Philippine earthworms should be further explored and harnessed for the production and utilization of vermicasts to mitigate the probable threats of invasive non-native species.
Author Contributions
Conceptualization, M.R.F.M., N.M.A. and M.C.M.O.; Methodology, validation, formal analysis, data curation, and writing—original draft preparation, M.R.F.M.; Writing—review and editing, M.R.F.M., N.M.A. and M.C.M.O.; Supervision and funding acquisition, M.C.M.O. All authors have read and agreed to the published version of the manuscript.
Funding
This research was funded by the Commission on Higher Education (CHED) through the K to 12 DARE TO Research, grant number 9610145-499-416.
Institutional Review Board Statement
Not applicable.
Informed Consent Statement
Not applicable.
Data Availability Statement
The data presented in this study are openly available as the content of reported tables and figures.
Acknowledgments
This research was conducted at the Microbial Ecology of Terrestrial and Aquatic Systems (METAS) Laboratory of the Institute of Biology, College of Science, University of the Philippines, Diliman, Quezon City, Philippines.
Conflicts of Interest
The authors declare no conflict of interest.
References
- Byzov, B.A.; Nechitaylo, T.Y.; Bumazhkin, B.K.; Kurakov, A.V.; Golyshin, P.N.; Zvyagintsev, D.G. Culturable microorganisms from the earthworm digestive tract. Microbiology 2009, 78, 360–368. [Google Scholar] [CrossRef]
- Nechitaylo, T.Y.; Yakimov, M.M.; Godinho, M.; Timmis, K.N.; Belogolova, E.; Byzov, B.A.; Kurakov, A.V.; Jones, D.L.; Golyshin, P.N. Effect of the earthworms Lumbricus terrestris and Aporrectodea caliginosa on bacterial diversity in soil. Microb. Ecol. 2010, 59, 574–587. [Google Scholar] [CrossRef] [PubMed]
- Scheu, S. Microbial activity and nutrient dynamics in earthworm casts (Lumbricidae). Biol. Fertil. Soils 1987, 5, 230–234. [Google Scholar] [CrossRef]
- de Menezes, A.B.; Prendergast-Miller, M.T.; Macdonald, L.M.; Toscas, P.; Baker, G.; Farrell, M.; Wark, T.; Richardson, A.E.; Thrall, P.H. Earthworm-induced shifts in microbial diversity in soils with rare versus established invasive earthworm populations. FEMS Microbiol. Ecol. 2018, 94, fiy051. [Google Scholar] [CrossRef] [PubMed]
- Aira, M.; Bybee, S.; Pérez-Losada, M.; Domínguez, J. Feeding on microbiomes: Effects of detritivory on the taxonomic and phylogenetic bacterial composition of animal manures. FEMS Microbiol. Ecol. 2015, 91, fiv117. [Google Scholar] [CrossRef]
- Alauzet, N.; Roussos, S.; Garreau, H.; Vert, M. Microflora dynamics in earthworms casts in an artificial soil (biosynthesol) containing lactic acid oligomers. Braz. Arch. Biol. Technol. 2001, 44, 113–119. [Google Scholar] [CrossRef]
- Dominguez, J.; Edwards, C.A.; Dominguez, J. The biology and population dynamics of Eudrilus eugeniae (Kinberg)(Oligochaeta) in cattle waste solids. Pedobiologia 2001, 45, 341–353. [Google Scholar] [CrossRef]
- Gómez-Brandón, M.; Aira, M.; Lores, M.; Domínguez, J. Epigeic earthworms exert a bottleneck effect on microbial communities through gut associated processes. PLoS ONE 2011, 6, e24786. [Google Scholar] [CrossRef]
- Emperor, G.N.; Kumar, K. Microbial population and activity on vermicompost of Eudrilus eugeniae and Eisenia fetida in different concentrations of tea waste with cow dung and kitchen waste mixture. Int. J. Curr. Microbiol. Appl. Sci. 2015, 4, 497–506. [Google Scholar]
- Yami, K.D.; Bhattarai, S.; Adhikari, S. Vermicomposting and micro flora analysis of vermicompost, vermicast and gut of red earthworm. Nepal J. Sci. Technol. 2003, 5, 121–126. [Google Scholar]
- Idowu, A.B.; Edema, M.O.; Adeyi, A.O. Distribution of bacteria and fungi in the earthworm Libyodrillus violaceous (Annelida: Oligochaeta), a native earthworm from Nigeria. Rev. Biol. Trop. 2006, 54, 49–58. [Google Scholar] [CrossRef] [PubMed]
- Singleton, D.R.; Hendrix, P.F.; Coleman, D.C.; Whitman, W.B. Identification of uncultured bacteria tightly associated with the intestine of the earthworm Lumbricus rubellus (Lumbricidae; Oligochaeta). Soil Biol. Biochem. 2003, 35, 1547–1555. [Google Scholar] [CrossRef]
- Chowdhury, A.; Hazra, A.K.; Mahajan, S.; Choudhury, J. Microbial communities of earthworm (Perionyx excavatus Perrier) gut, cast and adjacent soil in two different fields of west Bengal. Rec. Zool. Surv. India 2007, 107, 101–113. [Google Scholar] [CrossRef]
- Mba, C.C. Rock phosphate solubilizing and cellulolytic actinomycete isolates of earthworm casts. Environ. Manag. 1994, 18, 257–261. [Google Scholar] [CrossRef]
- Dedeke, G.A.; Babatunde, O.; Aladesida, A.A. Earthworm cast biomass under three managed ecosystems: Implication for soil fertility. Ethiop. J. Environ. Stud. Manag. 2015, 8, 464–470. [Google Scholar] [CrossRef][Green Version]
- Hmar, L.; Ramanujam, S.N. Earthworm cast production and physico-chemical properties in two agroforestry systems of Mizoram (India). Trop. Ecol. 2014, 55, 75–84. [Google Scholar]
- Jouquet, P.; Bottinelli, N.; Podwojewski, P.; Hallaire, V.; Tran Duc, T. Chemical and physical properties of earthworm casts as compared to bulk soil under a range of different land-use systems in Vietnam. Geoderma 2008, 146, 231–238. [Google Scholar] [CrossRef]
- Oyedele, D.J.; Schjønning, P.; Amusan, A.A. Physicochemical properties of earthworm casts and uningested parent soil from selected sites in southwestern Nigeria. Ecol. Eng. 2006, 28, 106–113. [Google Scholar] [CrossRef]
- Kizilkaya, R.; Hepşen, Ş. Microbiological properties in earthworm cast and surrounding soil amended with various organic wastes. Commun. Soil Sci. Plant Anal. 2007, 38, 2861–2876. [Google Scholar] [CrossRef]
- Dedeke, G.A.; Omemu, O.; Aladesida, A.A.; Museliu, F. Comparative microbial analysis of earthworm casts collected from Ikenne, Ogun state, Nigeria. Ethiop. J. Environ. Stud. Manag. 2010, 3, 57–63. [Google Scholar] [CrossRef]
- Chaoui, H.I.; Zibilske, L.M.; Ohno, T. Effects of earthworm casts and compost on soil microbial activity and plant nutrient availability. Soil Biol. Biochem. 2003, 35, 295–302. [Google Scholar] [CrossRef]
- Arancon, N.Q.; Edwards, C.A.; Bierman, P.; Welch, C.; Metzger, J.D. Influences of vermicomposts on field strawberries: 1. Effects on growth and yields. Bioresour. Technol. 2004, 93, 145–153. [Google Scholar] [CrossRef] [PubMed]
- Arancon, N.Q.; Edwards, C.A.; Bierman, P.; Metzger, J.D.; Lucht, C. Effects of vermicomposts produced from cattle manure, food waste and paper waste on the growth and yield of peppers in the field. Pedobiologia 2005, 49, 297–306. [Google Scholar] [CrossRef]
- Atiyeh, R.M.; Subler, S.; Edwards, C.A.; Bachman, G.; Metzger, J.D.; Shuster, W. Effects of vermicomposts and composts on plant growth in horticultural container media and soil. Pedobiologia 2000, 44, 579–590. [Google Scholar] [CrossRef]
- Azarmi, R.; Ziveh, P.S.; Satari, M.R. Effect of vermicompost on growth, yield and nutrition status of tomato (Lycopersicum esculentum). Pak. J. Biol. Sci. 2008, 11, 1797–1802. [Google Scholar] [CrossRef] [PubMed]
- Karmegam, N.; Daniel, T. Effect of application of vermicasts as layering media for an ornamental plant Codiaeum variegatum (L.) Bl. Dyn. Soil Dyn. Plant 2009, 3, 100–104. [Google Scholar]
- Rekha, G.S.; Kaleena, P.K.; Elumalai, D.; Srikumaran, M.P.; Maheswari, V.N. Effects of vermicompost and plant growth enhancers on the exo-morphological features of Capsicum annum (Linn.) Hepper. Int. J. Recycl. Org. Waste Agric. 2018, 7, 83–88. [Google Scholar] [CrossRef]
- Zhao, H.T.; Li, T.P.; Zhang, Y.; Hu, J.; Bai, Y.C.; Shan, Y.H.; Ke, F. Effects of vermicompost amendment as a basal fertilizer on soil properties and cucumber yield and quality under continuous cropping conditions in a greenhouse. J. Soils Sediments 2017, 17, 2718–2730. [Google Scholar] [CrossRef]
- Blakemore, R.J. Eco-taxonomic profile of an iconic vermicomposter—The ‘African nightcrawler’ earthworm, Eudrilus eugeniae (Kinberg, 1867). Afr. Invertebr. 2015, 56, 527–548. [Google Scholar] [CrossRef]
- Guerrero, R.D., III. Vermicomposting gets high marks in the tropics. BioCycle 2005, 46, 60–62. [Google Scholar]
- Guerrero, R.D., III; Guerrero, L.A. Production of vermicompost and earthworm biomass (Eudrilus eugeniae) for organic Nile tilapia (Oreochromis niloticus) culture in freshwater ponds. J. Fish. Aquac. 2014, 5, 154–157. [Google Scholar]
- Owa, S.O.; Olowoparija, S.B.; Aladesida, A.; Dedeke, G.A. Enteric bacteria and fungi of the Eudrilid earthworm Libyodrilus violaceus. Afr. J. Agric. Res. 2013, 8, 1760–1766. [Google Scholar] [CrossRef]
- Bityutskii, N.P.; Kaidun, P.I. The influence of earthworms on the mobility of microelements in soil and their availability for plants. Eurasian Soil Sci. 2008, 41, 1306–1313. [Google Scholar] [CrossRef]
- Aspe, N.M.; Manasan, R.E.; Manlavi, A.B.; Patiluna, M.L.E.; Sebido, M.A.B.; Obusan, M.C.M.; Simbahan, J.F.; James, S.W. The earthworm fauna of Palawan, Philippines with description of nineteen new pheretimoid species (Clitellata: Megascolecidae). J. Nat. Hist. 2021, 55, 733–797. [Google Scholar] [CrossRef]
- Aspe, N.M.; Obusan, M.C.M. Pheretimoid earthworms (Clitellata: Megascolecidae) cultivated in a vermifacility in Los Baños, Laguna, Philippines, with description of a new species. Zootaxa 2023, 5255, 101–112. [Google Scholar] [CrossRef]
- Mathipi, V.; De Mandal, S.; Chawngthu, Z.; Lalfelpuii, R.; Kumar, N.S.; Lalthanzara, H. Diversity and metabolic potential of earthworm gut microbiota in Indo-Myanmar biodiversity hotspot. J. Pure Appl. Microbiol. 2020, 14, 1503–1511. [Google Scholar] [CrossRef]
- Sapkota, R.; Santos, S.; Farias, P.; Krogh, P.H.; Winding, A. Insights into the earthworm gut multi-kingdom microbial communities. Sci. Total Environ. 2020, 727, 138301. [Google Scholar] [CrossRef]
- Frąc, M.; Oszust, K.; Lipiec, J. Community level physiological profiles (CLPP), characterization and microbial activity of soil amended with dairy sewage sludge. Sensors 2012, 12, 3253–3268. [Google Scholar] [CrossRef]
- Denier, J.; Faucon, M.P.; Dulaurent, A.M.; Guidet, J.; Kervroëdan, L.; Lamerre, J.; Houben, D. Earthworm communities and microbial metabolic activity and diversity under conventional, feed and biogas cropping systems as affected by tillage practices. Appl. Soil Ecol. 2022, 169, 104232. [Google Scholar] [CrossRef]
- Pot, S.; De Tender, C.; Ommeslag, S.; Delcour, I.; Ceusters, J.; Gorrens, E.; Debode, J.; Vandecasteele, B.; Vancampenhout, K. Understanding the shift in the microbiome of composts that are optimized for a better fit-for-purpose in growing media. Front. Microbiol. 2021, 12, 643679. [Google Scholar] [CrossRef]
- Wei, Z.; Wang, H.; Ma, C.; Li, S.; Wu, H.; Yuan, K.; Meng, X.; Song, Z.; Fang, X.; Zhao, Z. Unraveling the impact of long-term rice monoculture practice on soil fertility in a rice-planting meadow soil: A perspective from microbial biomass and carbon metabolic rate. Microorganisms 2022, 10, 2153. [Google Scholar] [CrossRef]
- Mudziwapasi, R.; Mlambo, S.S.; Chigu, N.L.; Kuipa, P.K.; Sanyika, W.T. Isolation and molecular characterization of bacteria from the gut of Eisenia fetida for biodegradation of 4,4 DDT. J. Appl. Biol. Biotechnol. 2016, 4, 41–47. [Google Scholar] [CrossRef]
- Bamidele, J.A.; Idowu, A.B.; Ademolu, K.O.; Atayese, A.O. Microbial diversity and digestive enzyme activities in the gut of earthworms found in sawmill industries in Abeokuta, Nigeria. Rev. Biol. Trop. 2014, 62, 1241–1249. [Google Scholar] [CrossRef][Green Version]
- Gothwal, R.K.; Nigam, V.K.; Mohan, M.K.; Sasmal, D.; Ghosh, P. Screening of nitrogen fixers from rhizospheric bacterial isolates associated with important desert plants. Appl. Ecol. Environ. Res. 2008, 6, 101–109. [Google Scholar] [CrossRef]
- Saiyad, S.A.; Jhala, Y.K.; Vyas, R.V. Comparative efficiency of five potash and phosphate solubilizing bacteria and their key enzymes useful for enhancing and improvement of soil fertility. Int. J. Sci. Res. Publ. 2015, 5, 1–6. [Google Scholar]
- Shanware, A.S.; Kalkar, S.A.; Trivedi, M.M. Potassium solubilisers: Occurrence, mechanism and their role as competent biofertilizers. Int. J. Curr. Microbiol. Appl. Sci. 2014, 3, 622–629. [Google Scholar]
- Sharon, J.A.; Hathwaik, L.T.; Glenn, G.M.; Imam, S.H.; Lee, C.C. Isolation of efficient phosphate solubilizing bacteria capable of enhancing tomato plant growth. J. Soil Sci. Plant Nutr. 2016, 16, 525–536. [Google Scholar] [CrossRef]
- Gryta, A.; Frąc, M.; Oszust, K. The application of the Biolog EcoPlate approach in ecotoxicological evaluation of dairy sewage sludge. Appl. Biochem. Biotechnol. 2014, 174, 1434–1443. [Google Scholar] [CrossRef] [PubMed]
- Muñiz, S.; Lacarta, J.; Pata, M.P.; Jiménez, J.J.; Navarro, E. Analysis of the diversity of substrate utilisation of soil bacteria exposed to Cd and earthworm activity using generalised additive models. PLoS ONE 2014, 9, e85057. [Google Scholar] [CrossRef] [PubMed]
- Lipiec, J.; Frąc, M.; Brzezińska, M.; Turski, M.; Oszust, K. Linking microbial enzymatic activities and functional diversity of soil around earthworm burrows and casts. Front. Microbiol. 2016, 7, 1361. [Google Scholar] [CrossRef]
- Mapile, M.R.F.; Obusan, M.C.M. Mineralization, biodegradation, and antagonistic activities of gut-associated bacteria and fungi of African nightcrawler Eudrilus eugeniae (Kinberg, 1867). Sci. Diliman 2020, 32, 42–67. [Google Scholar]
- Crumsey, J.M.; Le Moine, J.M.; Vogel, C.S.; Nadelhoffer, K.J. Historical patterns of exotic earthworm distributions inform contemporary associations with soil physical and chemical factors across a northern temperate forest. Soil Biol. Biochem. 2014, 68, 503–514. [Google Scholar] [CrossRef]
- Jouquet, P.; Thi, P.N.; Hong, H.N.; Henry-des-Tureaux, T.; Chevallier, T.; Tran Duc, T. Laboratory investigation of organic matter mineralization and nutrient leaching from earthworm casts produced by Amynthas khami. Appl. Soil Ecol. 2011, 47, 24–30. [Google Scholar] [CrossRef]
- Parle, J.N. A microbiological study of earthworm casts. J. Gen. Microbiol. 1963, 31, 13–22. [Google Scholar] [CrossRef]
- Mba, C.C. Rock phosphate solubilizing Streptosporangium isolates from casts of tropical earthworms. Soil Biol. Biochem. 1997, 29, 381–385. [Google Scholar] [CrossRef]
- Krishnamoorthy, R.V. Mineralization of phosphorus by faecal phosphatases of some earthworms of Indian tropics. Anim. Sci. 1990, 99, 509–518. [Google Scholar] [CrossRef]
- Suthar, S. Bioremediation of aerobically treated distillery sludge mixed with cow dung by using an epigeic earthworm Eisenia fetida. Environmentalist 2008, 28, 76–84. [Google Scholar] [CrossRef]
- Atiyeh, R.M.; Domínguez, J.; Subler, S.; Edwards, C.A. Changes in biochemical properties of cow manure during processing by earthworms (Eisenia andrei, Bouché) and the effects on seedling growth. Pedobiologia 2000, 44, 709–724. [Google Scholar] [CrossRef]
- Edwards, C.A.; Dominguez, J.; Arancon, N.Q. The influence of vermicompost on plant growth and pest incidence. In Soil Zoology for Sustainable Development in the 21st Century; Shakir, S.H., Mikhal, W.Z.A., Eds.; IUCN: Cairo, Egypt, 2004; pp. 397–420. [Google Scholar]
- Ferreras, L.; Gómez, E.; Toresani, S.; Firpo, I.; Rotondo, R. Effect of organic amendments on some physical, chemical and biological properties in a horticultural soil. Bioresour. Technol. 2006, 97, 635–640. [Google Scholar] [CrossRef]
- Hidalgo, P.R.; Matta, F.B.; Harkess, R.L. Physical and chemical properties of substrates containing earthworm castings and effects on marigold growth. HortScience 2006, 41, 1474–1476. [Google Scholar] [CrossRef]
- Hidalgo, P.R.; Harkess, R.L. Earthworm castings as a substrate amendment for chrysanthemum production. Hortscience 2002, 37, 1035–1039. [Google Scholar] [CrossRef]
- De la Vega, A. Vermicomposting: The Future of Sustainable Agriculture and Organic Waste Management. Lessons from the USA and Cuba; Royal Horticultural Society: London, UK, 2016; pp. 1–48. [Google Scholar]
- Honeker, L.K.; Gullo, C.F.; Neilson, J.W.; Chorover, J.; Maier, R.M. Effect of re-acidification on buffalo grass rhizosphere and bulk microbial communities during phytostabilization of metalliferous mine tailings. Front. Microbiol. 2019, 10, 1209. [Google Scholar] [CrossRef] [PubMed]
- Proença, D.N.; Whitman, W.B.; Varghese, N.; Shapiro, N.; Woyke, T.; Kyrpides, N.C.; Morais, P.V. Arboriscoccus pini gen. nov., sp. nov., an endophyte from a pine tree of the class Alphaproteobacteria, emended description of Geminicoccus roseus, and proposal of Geminicoccaceae fam. nov. Syst. Appl. Microbiol. 2018, 41, 94–100. [Google Scholar] [CrossRef]
- Chen, X.; Marszałkowska, M.; Reinhold-Hurek, B. Jasmonic acid, not salicyclic acid restricts endophytic root colonization of rice. Front. Plant Sci. 2020, 10, 1758. [Google Scholar] [CrossRef] [PubMed]
- Faoro, H.; Rene Menegazzo, R.; Battistoni, F.; Gyaneshwar, P.; do Amaral, F.P.; Taulé, C.; Rausch, S.; Galvão, P.G.; de los Santos, C.; Mitra, S.; et al. The oil-contaminated soil diazotroph Azoarcus olearius DQS-4T is genetically and phenotypically similar to the model grass endophyte Azoarcus sp. BH72. Environ. Microbiol. Rep. 2017, 9, 223–238. [Google Scholar] [CrossRef]
- Pankievicz, V.C.S.; do Amaral, F.P.; Ané, J.M.; Stacey, G. Diazotrophic bacteria and their mechanisms to interact and benefit cereals. Mol. Plant Microbe Interact. 2021, 34, 491–498. [Google Scholar] [CrossRef]
- Grönemeyer, J.L.; Bünger, W.; Reinhold-Hurek, B. Bradyrhizobium namibiense sp. nov., a symbiotic nitrogen-fixing bacterium from root nodules of Lablab purpureus, hyacinth bean, in Namibia. Int. J. Syst. Evol. Microbiol. 2017, 67, 4884–4891. [Google Scholar] [CrossRef]
- Munakata, Y.; Spina, R.; Slezack-Deschaumes, S.; Genestier, J.; Hehn, A.; Laurain-Mattar, D. Screening of endophytic bacteria of Leucojum aestivum ‘gravety giant’ as a potential source of alkaloids and as antagonist to some plant fungal pathogens. Microorganisms 2022, 10, 2089. [Google Scholar] [CrossRef]
- Muratova, A.; Golubev, S.; Romanova, V.; Sungurtseva, I.; Nurzhanova, A. Effect of heavy-metal-resistant PGPR inoculants on growth, rhizosphere microbiome and remediation potential of Miscanthus × giganteus in zinc-contaminated soil. Microorganisms 2023, 11, 1516. [Google Scholar] [CrossRef]
- Choi, A.; Cha, I.T.; Lee, K.E.; Son, Y.K.; Yu, J.; Seol, D. The role of Flavobacterium enshiense R6S-5-6 in the wetland ecosystem revealed by whole-genome analysis. Curr. Microbiol. 2023, 80, 83. [Google Scholar] [CrossRef]
- Nouioui, I.; del Carmen Montero-Calasanz, M.; Ghodhbane-Gtari, F.; Rohde, M.; Tisa, L.S.; Klenk, H.P.; Gtari, M. Frankia discariae sp. nov.: An infective and effective microsymbiont isolated from the root nodule of Discaria trinervis. Arch. Microbiol. 2017, 199, 641–647. [Google Scholar] [CrossRef] [PubMed]
- Viulu, S.; Nakamura, K.; Okada, Y.; Saitou, S.; Takamizawa, K. Geobacter luticola sp. nov., an Fe (III)-reducing bacterium isolated from lotus field mud. Int. J. Syst. Evol. Microbiol. 2013, 63, 442–448. [Google Scholar] [CrossRef] [PubMed]
- Fan, M.C.; Guo, Y.Q.; Zhang, L.P.; Zhu, Y.M.; Chen, W.M.; Lin, Y.B.; Wei, G.H. Herbaspirillum robiniae sp. nov., isolated from root nodules of Robinia pseudoacacia in a lead–zinc mine. Int. J. Syst. Evol. Microbiol. 2018, 68, 1300–1306. [Google Scholar] [CrossRef] [PubMed]
- Nordstedt, N.P.; Jones, M.L. Isolation of rhizosphere bacteria that improve quality and water stress tolerance in greenhouse ornamentals. Front. Plant Sci. 2020, 11, 826. [Google Scholar] [CrossRef]
- Tapia-García, E.Y.; Hernández-Trejo, V.; Guevara-Luna, J.; Rojas-Rojas, F.U.; Arroyo-Herrera, I.; Meza-Radilla, G.; Vasquez-Murrieta, M.S.; Estrada-de Los Santos, P. Plant growth-promoting bacteria isolated from wild legume nodules and nodules of Phaseolus vulgaris L. trap plants in central and southern Mexico. Microbiol. Res. 2020, 239, 126522. [Google Scholar] [CrossRef]
- Yoneda, Y.; Yamamoto, K.; Makino, A.; Tanaka, Y.; Meng, X.Y.; Hashimoto, J.; Shin-ya, K.; Satoh, N.; Fujie, M.; Toyama, T.; et al. Novel plant-associated acidobacteria promotes growth of common floating aquatic plants, duckweeds. Microorganisms 2021, 9, 1133. [Google Scholar] [CrossRef]
- Bao, Z.; Okubo, T.; Kubota, K.; Kasahara, Y.; Tsurumaru, H.; Anda, M.; Ikeda, S.; Minamisawa, K. Metaproteomic identification of diazotrophic methanotrophs and their localization in root tissues of field-grown rice plants. Appl. Environ. Microbiol. 2014, 80, 5043–5052. [Google Scholar] [CrossRef]
- Chen, Y.; Sun, R.; Sun, T.; Liang, Y.; Jiang, Y.; Sun, B. Organic amendments shift the phosphorus-correlated microbial co-occurrence pattern in the peanut rhizosphere network during long-term fertilization regimes. Appl. Soil Ecol. 2018, 124, 229–239. [Google Scholar] [CrossRef]
- Yamamoto, K.; Shiwa, Y.; Ishige, T.; Sakamoto, H.; Tanaka, K.; Uchino, M.; Tanaka, N.; Oguri, S.; Saitoh, H.; Tsushima, S. Bacterial diversity associated with the rhizosphere and endosphere of two halophytes: Glaux maritima and Salicornia europaea. Front. Microbiol. 2018, 9, 2878. [Google Scholar] [CrossRef]
- Yu, Z.; Chang, M.; Wu, M.; Yang, G.; Zhou, S.; Zhuang, L. Pseudomonas oryzae sp. nov. isolated from a paddy soil in South China. Arch. Microbiol. 2013, 195, 815–822. [Google Scholar] [CrossRef]
- Morvan, S.; Paré, M.C.; Schmitt, A.; Lafond, J.; Hijri, M. Limited effect of thermal pruning on wild blueberry crop and its root-associated microbiota. Front. Plant Sci. 2022, 13, 954935. [Google Scholar] [CrossRef] [PubMed]
- Oberhofer, M.; Hess, J.; Leutgeb, M.; Gössnitzer, F.; Rattei, T.; Wawrosch, C.; Zotchev, S.B. Exploring actinobacteria associated with rhizosphere and endosphere of the native alpine medicinal plant Leontopodium nivale subspecies alpinum. Front. Microbiol. 2019, 10, 2531. [Google Scholar] [CrossRef] [PubMed]
- Chee-Sanford, J.C.; Frost, J.W.; Fries, M.R.; Zhou, J.; Tiedje, J.M. Evidence for acetyl coenzyme A and cinnamoyl coenzyme A in the anaerobic toluene mineralization pathway in Azoarcus tolulyticus Tol-4. Appl. Environ. Microbiol. 1996, 62, 964–973. [Google Scholar] [CrossRef] [PubMed]
- Rabus, R.; Wöhlbrand, L.; Thies, D.; Meyer, M.; Reinhold-Hurek, B.; Kämpfer, P. Aromatoleum gen. nov., a novel genus accommodating the phylogenetic lineage including Azoarcus evansii and related species, and proposal of Aromatoleum aromaticum sp. nov., Aromatoleum petrolei sp. nov., Aromatoleum bremense sp. nov., Aromatoleum toluolicum sp. nov. and Aromatoleum diolicum sp. nov. Int. J. Syst. Evol. Microbiol. 2019, 69, 982–997. [Google Scholar] [CrossRef]
- Zhou, J.; Fries, M.R.; Chee-Sanford, J.C.; Tiedje, J.M. Phylogenetic analyses of a new group of denitrifiers capable of anaerobic growth on toluene and description of Azoarcus tolulyticus sp. nov. Int. J. Syst. Evol. Microbiol. 1995, 45, 500–506. [Google Scholar] [CrossRef]
- Takeda, M.; Kamagata, Y.; Ghiorse, W.C.; Hanada, S.; Koizumi, J.I. Caldimonas manganoxidans gen. nov., sp. nov., a poly (3-hydroxybutyrate)-degrading, manganese-oxidizing thermophile. Int. J. Syst. Evol. Microbiol. 2002, 52, 895–900. [Google Scholar] [CrossRef]
- Mistry, A.N.; Kachenchart, B.; Wongthanaroj, A.; Somwangthanaroj, A.; Luepromchai, E. Rapid biodegradation of high molecular weight semi-crystalline polylactic acid at ambient temperature via enzymatic and alkaline hydrolysis by a defined bacterial consortium. Polym. Degrad. Stab. 2022, 202, 110051. [Google Scholar] [CrossRef]
- Mistry, A.N.; Kachenchart, B.; Pinyakong, O.; Assavalapsakul, W.; Jitpraphai, S.M.; Somwangthanaroj, A.; Luepromchai, E. Bioaugmentation with a defined bacterial consortium: A key to degrade high molecular weight polylactic acid during traditional composting. Bioresour. Technol. 2023, 367, 128237. [Google Scholar] [CrossRef]
- Taş, N.; Van Eekert, M.H.; De Vos, W.M.; Smidt, H. The little bacteria that can–diversity, genomics and ecophysiology of ‘Dehalococcoides’ spp. in contaminated environments. Microb. Biotechnol. 2010, 3, 389–402. [Google Scholar] [CrossRef]
- Papassiopi, N.; Vaxevanidou, K.; Paspaliaris, I. Investigating the use of iron reducing bacteria for the removal of arsenic from contaminated soils. Water Air Soil Pollut. 2003, 3, 81–90. [Google Scholar] [CrossRef]
- Vaxevanidou, K.; Christou, C.; Kremmydas, G.F.; Georgakopoulos, D.G.; Papassiopi, N. Role of indigenous arsenate and iron (III) respiring microorganisms in controlling the mobilization of arsenic in a contaminated soil sample. Bull. Environ. Contam. Toxicol. 2015, 94, 282–288. [Google Scholar] [CrossRef] [PubMed]
- Yoon, M.H.; Im, W.T. Flavisolibacter ginsengiterrae gen. nov., sp. nov. and Flavisolibacter ginsengisoli sp. nov., isolated from ginseng cultivating soil. Int. J. Syst. Evol. Microbiol. 2007, 57, 1834–1839. [Google Scholar] [CrossRef] [PubMed]
- Wischgoll, S.; Heintz, D.; Peters, F.; Erxleben, A.; Sarnighausen, E.; Reski, R.; Van Dorsselaer, A.V.; Boll, M. Gene clusters involved in anaerobic benzoate degradation of Geobacter metallireducens. Mol. Microbiol. 2005, 58, 1238–1252. [Google Scholar] [CrossRef] [PubMed]
- He, Y.; Gong, Y.; Su, Y.; Zhang, Y.; Zhou, X. Bioremediation of Cr (VI) contaminated groundwater by Geobacter sulfurreducens: Environmental factors and electron transfer flow studies. Chemosphere 2019, 221, 793–801. [Google Scholar] [CrossRef]
- Tsao, S.; Wei, D.J.; Chang, Y.T.; Lee, J.F. Aerobic biodegradation of microcystin-LR by an indigenous bacterial mixed culture isolated in Taiwan. Int. Biodeterior. Biodegrad. 2017, 124, 101–108. [Google Scholar] [CrossRef]
- Corteselli, E.M.; Aitken, M.D.; Singleton, D.R. Description of Immundisolibacter cernigliae gen. nov., sp. nov., a high-molecular-weight polycyclic aromatic hydrocarbon-degrading bacterium within the class Gammaproteobacteria, and proposal of Immundisolibacterales ord. nov. and Immundisolibacteraceae fam. nov. Int. J. Syst. Evol. Microbiol. 2017, 67, 925–931. [Google Scholar]
- Kane, S.R.; Chakicherla, A.Y.; Chain, P.S.; Schmidt, R.; Shin, M.W.; Legler, T.C.; Scow, K.M.; Larimer, F.W.; Lucas, S.M.; Richardson, P.M.; et al. Whole-genome analysis of the methyl tert-butyl ether-degrading beta-proteobacterium Methylibium petroleiphilum PM1. J. Bacteriol. 2007, 189, 1931–1945. [Google Scholar] [CrossRef]
- Nakatsu, C.H.; Hristova, K.; Hanada, S.; Meng, X.Y.; Hanson, J.R.; Scow, K.M.; Kamagata, Y. Methylibium petroleiphilum gen. nov., sp. nov., a novel methyl tert-butyl ether-degrading methylotroph of the Betaproteobacteria. Int. J. Syst. Evol. Microbiol. 2006, 56, 983–989. [Google Scholar] [CrossRef]
- Schmidt, R.; Battaglia, V.; Scow, K.; Kane, S.; Hristova, K.R. Involvement of a novel enzyme, MdpA, in methyl tert-butyl ether degradation in Methylibium petroleiphilum PM1. Appl. Environ. Microbiol. 2008, 74, 6631–6638. [Google Scholar] [CrossRef]
- Stackebrandt, E.; Verbarg, S.; Frühling, A.; Busse, H.J.; Tindall, B.J. Dissection of the genus Methylibium: Reclassification of Methylibium fulvum as Rhizobacter fulvus comb. nov., Methylibium aquaticum as Piscinibacter aquaticus gen. nov., comb. nov. and Methylibium subsaxonicum as Rivibacter subsaxonicus gen. nov., comb. nov. and emended descriptions of the genera Rhizobacter and Methylibium. Int. J. Syst. Evol. Microbiol. 2009, 59, 2552–2560. [Google Scholar] [CrossRef]
- Hamamura, N.; Page, C.; Long, T.; Semprini, L.; Arp, D.J. Chloroform cometabolism by butane-grown CF8, Pseudomonas butanovora, and Mycobacterium vaccae JOB5 and methane-grown Methylosinus trichosporium OB3b. Appl. Environ. Microbiol. 1997, 63, 3607–3613. [Google Scholar] [CrossRef]
- Urana, R.; Yadav, J.; Panchal, S.; Sharma, P.; Singh, N. Phytoremediation of PAH compounds by microbial communities in sodic soil. Int. J. Phytoremediation 2023, 25, 1501–1509. [Google Scholar] [CrossRef] [PubMed]
- Brereton, N.J.B.; Gonzalez, E.; Desjardins, D.; Labrecque, M.; Pitre, F.E. Co-cropping with three phytoremediation crops influences rhizosphere microbiome community in contaminated soil. Sci. Total Environ. 2020, 711, 135067. [Google Scholar] [CrossRef]
- Nogi, Y.; Yoshizumi, M.; Hamana, K.; Miyazaki, M.; Horikoshi, K. Povalibacter uvarum gen. nov., sp. nov., a polyvinyl-alcohol-degrading bacterium isolated from grapes. Int. J. Syst. Evol. Microbiol. 2014, 64, 2712–2717. [Google Scholar] [CrossRef] [PubMed]
- Brune, A.; Ludwig, W.; Schink, B. Propionivibrio limicola sp. nov., a fermentative bacterium specialized in the degradation of hydroaromatic compounds, reclassification of Propionibacter pelophilus as Propionivibrio pelophilus comb. nov. and amended description of the genus Propionivibrio. Int. J. Syst. Evol. Microbiol. 2002, 52, 441–444. [Google Scholar] [CrossRef] [PubMed]
- Bazzi, W.; Abou Fayad, A.G.; Nasser, A.; Haraoui, L.P.; Dewachi, O.; Abou-Sitta, G.; Nguyen, V.K.; Abara, A.; Karah, N.; Landecker, H.; et al. Heavy metal toxicity in armed conflicts potentiates AMR in A. baumannii by selecting for antibiotic and heavy metal co-resistance mechanisms. Front. Microbiol. 2020, 11, 68. [Google Scholar] [CrossRef]
- Fahrbach, M.; Kuever, J.; Remesch, M.; Huber, B.E.; Kampfer, P.; Dott, W.; Hollender, J. Steroidobacter denitrificans gen. nov., sp. nov., a steroidal hormone-degrading gammaproteobacterium. Int. J. Syst. Evol. Microbiol. 2008, 58, 2215–2223. [Google Scholar] [CrossRef]
- Fahrbach, M.; Krauss, M.; Preiss, A.; Kohler, H.P.E.; Hollender, J. Anaerobic testosterone degradation in Steroidobacter denitrificans–identification of transformation products. Environ. Pollut. 2010, 158, 2572–2581. [Google Scholar] [CrossRef]
- Ahmed, B.; Floc’h, J.B.; Lahrach, Z.; Hijri, M. Phytate and microbial suspension amendments increased soybean growth and shifted microbial community structure. Microorganisms 2021, 9, 1803. [Google Scholar] [CrossRef]
- Oshiki, M.; Fukushima, T.; Kawano, S.; Nakagawa, J. Draft genome sequence of Thiohalobacter thiocyanaticus strain FOKN1, a neutrophilic halophile capable of thiocyanate degradation. Genome Announc. 2017, 5, 10–1128. [Google Scholar] [CrossRef]
Disclaimer/Publisher’s Note: The statements, opinions and data contained in all publications are solely those of the individual author(s) and contributor(s) and not of MDPI and/or the editor(s). MDPI and/or the editor(s) disclaim responsibility for any injury to people or property resulting from any ideas, methods, instructions or products referred to in the content. |
© 2023 by the authors. Licensee MDPI, Basel, Switzerland. This article is an open access article distributed under the terms and conditions of the Creative Commons Attribution (CC BY) license (https://creativecommons.org/licenses/by/4.0/).